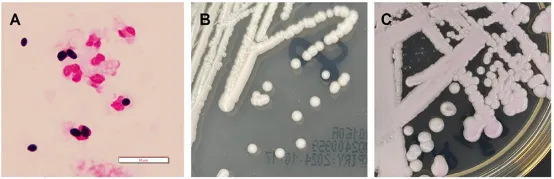
1736297397875

学术前沿丨广西首例临床分离的耳念珠菌检测与院内感染防控
2025年1月6日,广西国际壮医医院联合上海市东方医院(同济大学附属东方医院)撰写的《广西首例儿童骨髓移植分离的耳念珠菌检测和感染控制》一文,在国际期刊《Infection and Drug Resistance》(IF:2.9)正式发表。此论文的发表,代表国壮耳念珠菌检测和防控经验得到了国际同行的认可。

耳念珠菌作为“超级真菌”,定植能力强、传播速度快,具有多重耐药性,可能对医院的院感防控和其他患者造成一定的威胁,需要及时防控。医院多次组织针对性的耳念珠菌院感防控培训,检验科和医院感染管理办公室主动联系上海市真菌监测网寻求真菌院感防控经验,提高医护人员对耳念珠菌感染防控的认识和防范技能。为更早、更精准发现潜在的感染和监控耳念珠菌定植、传播情况,检验科在发现科室现有的耳念珠菌培养、MALDI-TOF鉴定等方法上存在不足,以及标本培养时间太长等问题后,立即寻求华东地区真菌耐药监测网(ECIFIG)牵头单位同济大学附属东方医院检验科的帮助。通过全基因组测序分析揭示了本研究分离的耳念珠菌为分枝I,并用敏感度较高的聚合酶链反应(PCR)方法定期对采集的患者腋窝、腹股沟等部位和医院环境物表的样本进行检测,既提高了阳性检出率,又实现了早发现、早隔离、早治疗。
▲图A为尿液离心标本 X1000倍光学显微镜下的耳念珠菌菌体特征;图B和图C为在SDA培养基和真菌显色培养基, 35 °C下培养3天后,耳念珠菌的菌落特征。
检验科联合院感科和其他科室成功处置耳念珠菌防控后,全面梳理了相关细节,并认真撰写了《广西首例儿童骨髓移植分离的耳念珠菌检测和感染控制》一文,成功发表于英国杂志《Infection and Drug Resistance》上(影响因子2.9分),为临床耳念珠菌的检出和防控提供了宝贵经验。
论文链接:https://www.dovepress.com/the-first-case-of-candida-auris-detection-and-infection-control-in-a-p-peer-reviewed-fulltext-article-IDR

单点登录
账号密码登录